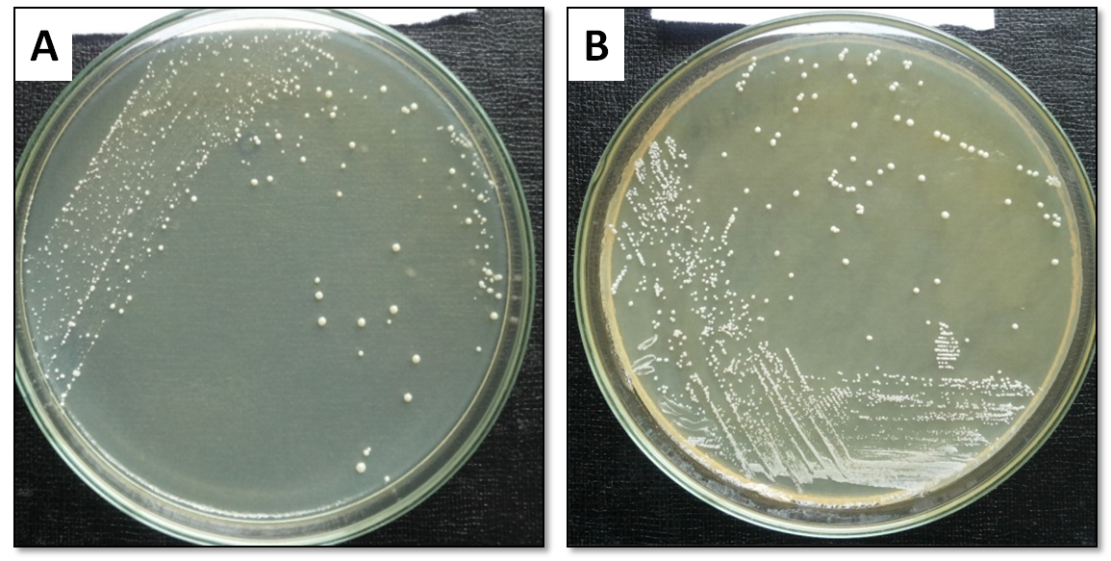
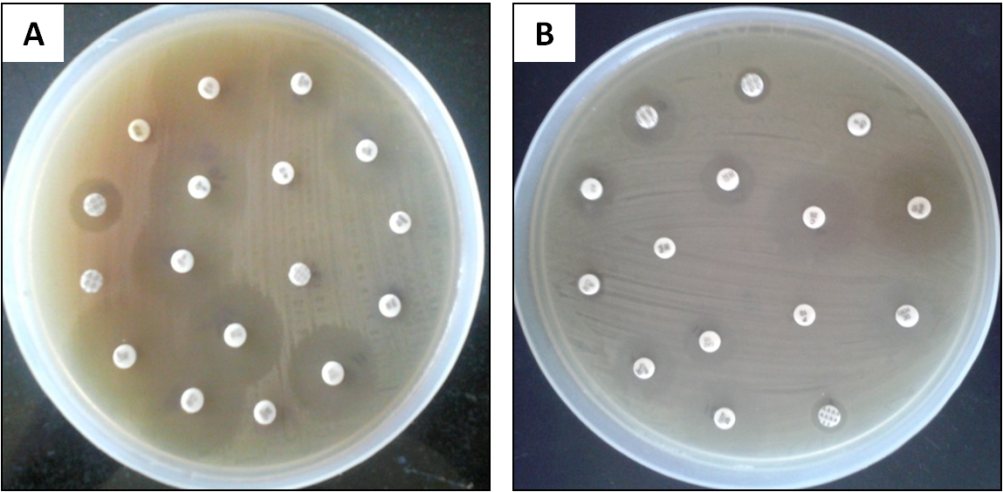
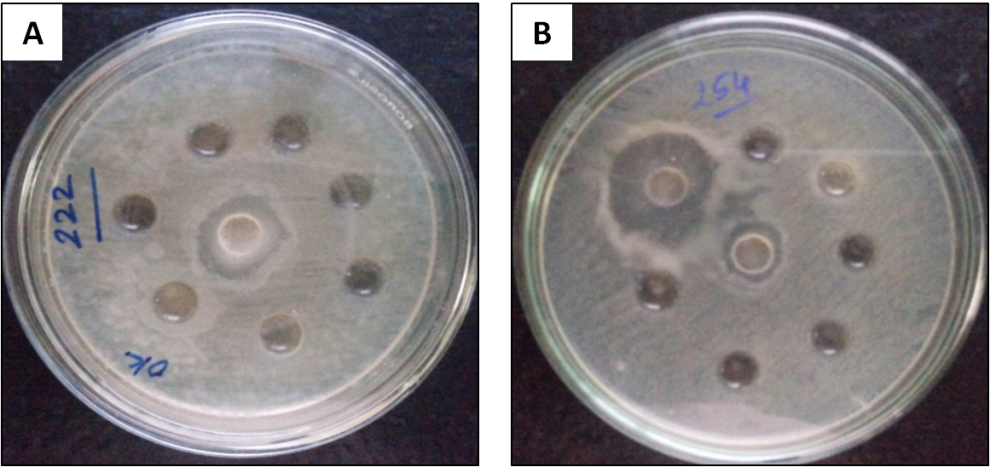

Int J Pharm Pharm Sci, Vol 8, Issue 12, 277-286Original Article
DEVELOPMENT OF IN VITRO METHODOLOGIES FOR INHIBITION OF PATHOGENIC BACTERIA BY POTENTIAL PROBIOTIC LACTOBACILLUS SPS; AN EVIDENCE FOR PRODUCTION OF ANTIMICROBIAL SUBSTANCES
PRABHURAJESHWAR C.1, KELMANI CHANDRAKANTH R.1*
1Medical Biotechnology and Phage Therapy Laboratory, Department of Post-Graduate Studies and Research in Biotechnology, Gulbarga University, Gulbarga 585106, Karnataka, India
Email: ckelmani@gmail.com
Received: 25 Aug 2016 Revised and Accepted: 24 0ct 2016
ABSTRACT
Objective: Probiotic products consist of specific strains of live bacteria that have potentially favorable health effects. A number of studies provide evidence that milk products with probiotics may be beneficial for digestive health and may improve various digestive problems. The purpose of the present study was to investigate Lactobacillus species with potential activities isolated from different cheese samples of local market.
Methods: A total 42 lactic acid bacteria strains were isolated, fourteen (14/42) best Lactobacillus isolates were selected by preliminary screening as potential probiotics with antimicrobial activity against pathogenic bacteria. All the fourteen Lactobacillus isolates were then characterized in vitro for their probiotic features and antimicrobial activities against pathogens.
Results: The results noticed that all selected Lactobacillus isolates (CH3, CH4 and CH6) were screened and confirmed as Lactobacillus. The isolates were able to grow at different pH, NaCl and bile salts, also exhibited the best antimicrobial activities against pathogens. All the isolates were susceptible to antibiotics used and isolates were also revealed the noticeable aggregation and hydrophobicity studies.
Conclusion: Selected Lactobacillus isolates were considered as ideal, effective probiotic bacteria. Thus, they could be examined further and contribute to preventing and controlling several infections associated with intestine and for human health benefits.
Keywords: Cheese, Antimicrobial activity, Antibiotic susceptibility test, Lactic acid bacteria, Probiotics
© 2016 The Authors. Published by Innovare Academic Sciences Pvt Ltd. This is an open access article under the CC BY license (http://creativecommons.org/licenses/by/4. 0/)
DOI: http://dx.doi.org/10.22159/ijpps.2016v8i12.14894
INTRODUCTION
The term probiotic was defined as “a live microbial feed supplement which beneficially affects the host animal by improving its microbial balance’’ [1]. Probiotic bacteria may produce various compounds, which are inhibitory to the pathogen’s growth, which include organic acids (lactic and acetic acids), bacteriocins, and reuterin. The organic acids not only lower the pH, thereby affecting the growth of the pathogen, but they can also be toxic to the microbes [2]. There is increasing evidence that probiotics are beneficial in gastrointestinal disturbances, such as diarrhoea, dysentery, typhoid etc [2]. It is important to underline when considering the effectiveness and biological activity of probiotics, prebiotics or their combination (symbiotic) that they are food products and not drugs.
The concept of using live bacterial species such as Lactobacillus sps with health benefit has received a great deal of attention in recent years. It is well known that the gastrointestinal (GI) tract is the home to a vast number of bacterial species, with vital roles in maintaining GI functionality including up to 70% of the immune system activity [3]. The probiotics are recommended as a preventive approach to maintain the balance of intestinal microbiota [4]. Amongst various microbiota, Lactobacillus sps is especially important for the maintenance of the human intestinal microbial ecosystem [5] which, in turn, may affect the quality of life. It has been indicated that the disturbances in the normal microbiota of the GI tract may lead to dysbiosis and ultimately clinical disease expression [6].
Lactobacillus sps that have wide spread use in fermented food production [7] and are considered as generally recognised as safe organisms and can be safely used for medical and veterinary applications [8]. In food industry, Lactobacillus sps are widely used as starter cultures and has been cited to be part of human microbiota [9, 10]. In raw milk and dairy products such as cheese, yoghurts and fermented milks, Lactobacilli are naturally present or added internationally, for technological reasons or to generate a health benefit for the consumer [11] and cheese is one of the best-known foods that contain probiotics [12]. From the health point of view, ingestion of live cells of certain species and strains the probiotic concept of Lactobacilli in adequate amounts is believed to confer several beneficial physiological effects on the host [13]. The criteria for the in vitro selection of Lactobacilli to be used as health-promoting, probiotic ingredients, in food and pharmaceutical preparations include antibiotic tolerance as well as the production of lactic acid that inhibits the growth of other microorganisms, which allow them to be established in the intestinal tract [14]. Bile tolerance [15] and gastric juice resistance [16] are other important characteristics of probiotic lactobacillus sps used as adjuncts because they unable them to survive, to grow and to perform their beneficial action in the gastrointestinal tract.
In the Gulbarga district and its surrounding region of Karnataka state, dairy products; cheese is possibly the oldest fermented milk product known and consumed by large sectors of the population as a part of their daily diet. In most of the urban areas of Karnataka state, different types of traditional cheese are found, but their probiotic role was not studied. Fusion of probiotic microorganisms (isolated from primitive cheese) in market of cheese can positively enhance health status of longer segment of communities. So this study is aimed to isolate the effective Lactobacillus isolates isolated from different products of cheese available at milk parlours and to determine the in vitro probiotic properties such as pH, NaCl tolerance, bile, antibiotic susceptibility profile, antimicrobial activity, aggregation studies and cell-surface hydrophobicity capacity of potentially selected probiotic Lactobacillus sps were demonstrated in controlling the growth of pathogenic strains.
MATERIALS AND METHODS
Material
Samples and other materials used in this research obtained from different companies of cheese, which are commercially available at the local milk vendors in city market of Gulbarga and all other chemicals were procured from Hi-media private limited, Bangalore.
Collection of samples
Due to their high association with health benefits dates among the consumers of Gulbarga and its surrounding region of Karnataka state, the dairy product; cheese samples were collected randomly with different companies from retailers in the market of Gulbarga. The samples were transferred in transport media (stored at 4 °C) within 1hr to the laboratory for microbiological analysis and processed within 24 h, further stored aseptically in low refrigerator temperature to protect normal flora and avoid from contamination.
Preliminary screening
In order to rapidly isolate acid and bile resistant bacteria from the plenteous microflora of cheese samples, the preliminary screening in phosphate buffer solution with pH 3.0and 6.0 was performed for 3-6 h.
Isolation of Lactobacillus sps
The bacteria Lactobacillus sps were isolated from cheese by using MRS (de Man, Rogosa and Sharpe) medium. Each sample containing Ten gram of cheese was homogenized with sterile phosphate buffer solution (2% w/v) at 30-40 °C in a stomacher 200-400 circulator (Remi make, India). Then a volume of 2 ml of each dilution was added into 20 ml MRS broth (pH 6.5) and incubated at 37 °C for 24 h. Finally, the single colony of bacteria was isolated by observing their colony morphology and some biochemical tests (Gram staining, catalase and oxidase and motility test) and the culture were maintained in MRS (Obtained from Hi-media Pvt. Ltd, Bangalore) broth at 6.5 [17].
Identification of Lactobacillus sps
The isolated bacteria were identified as Lactobacillus sps by observing their morphological characteristics and by means Gram staining, motility, catalase, oxidase test and milk coagulation activities. The confirmed Lactobacillus isolates were further preserved at MRS broth with skim milk (10%) and glycerol (30%) in-20 °C. At last complimentary of isolated Lactobacillus isolates was determined with some standard Lactobacillus sps.
Optical growth at different pH
For the determination of the optimal growth at different pH of Lactobacillus isolates, a single isolated colony was subcultured in MRS broth, from that 1% (v/v) fresh overnight culture of Lactobacillus isolated with varying pH between 2-8, adjusted to different pH using NaOH (1.0M) or HCl (1.0M) and incubated at 37 °C for 24 h. After 24h of incubation growth of the bacteria were measured using a spectrophotometer, reading the optical density at 600 nm against the uninoculated broth to observe the ability of the growth of Lactobacillus isolates under the different pH values [18].
Bile salt tolerance
The capability of strains to tolerate bile salts was determined according to the modified method of Gilliland and colleagues [19]. Lactobacillus isolates were tested for prompt growth in MRS broth medium with and without the addition of bile salts. MRS broth was prepared with the different concentration of bile salts between 0.5-2.5% and added to 5 ml of the test tube and sterilized at 121 °C for 15 min, 0.1 ml of Lactobacillus isolates were inoculated, and bacterial growth was monitored by measuring absorbance at 600 nm after incubation for 18-24 h at 37 °C.
Assessment for NaCl tolerance
For the determination of NaCl tolerance, MRS broth containing different NaCl concentration between 1-6% was sterilized, each test tube was inoculated with 1% (v/v) fresh overnight culture of Lactobacillus and incubated at 37 °C for 24 h. After the incubation, their growth was determined by observing their turbidity at 600 nm.
Antibiotic susceptibility test
According to the standard working procedures, antibiotic susceptibility tests were done on Mueller-Hinton agar (Hi-media Pvt Ltd, India) using Kirby-Bauer disk diffusion method [20]. Various antibiotic with different classes were used; tetracycline (30 µg), ampicillin (30 µg), erythromycin (15 µg), chloramphenicol (30 µg), gentamicin (10 µg), ciprofloxacin (5 µg), cephalotin (30 µg), cotrimoxazole (25 µg), ceftriaxone (30 µg), amoxicillin (10 µg), amoxiclav (10 µg), clindamycin (30 µg), amikacin (10 µg), cefuroxime (30 µg), oxacillin (10 µg), vancomycin (30 µg), Neomycin (10 µg) and sulfamethizole (10 µg) (Hi-media, India). Resistance and sensitivity pattern data were interpreted according to National Committee for Clinical laboratory Standards [21]. Reference strains of Lactobacillus fermentum NCDC 141 and Lactobacillus rhamnosus NCDC 329 (National Collection of Dairy Cultures, Karnal, India) were used for quality control for antibiotic susceptibility tests.
Antimicrobial (antagonistic) activity of Lactobacillus isolates
Antimicrobial activity of all collected Lactobacillus isolates against test pathogens was determined by Agar-well diffusion method according to Ashraf et al. [22]. Staphylococcus aureus (MTCC 96), Enterococcus faecalis (MTCC439), Klebsiella pneumonia (MTCC 432), Pseudomonas aerugenosa (MTCC 7925), E. coli (MTCC 443), Salmonella typhii (MTCC734), and Shigella spp (MTCC 13313) acquired from Microbial type culture collection Chandigarh, India, were used as test pathogens. A volume of 50-100 µl of the cell-free supernatant of each Lactobacillus isolates was filled in 7 mm diameter well in the nutrient agar including the test pathogens. The diameter of the clear inhibition zone was measured after 24 h of incubation. Each experiment was performed in triplicate.
Characterisation of antimicrobial substances
The effectively selected probiotic Lactobacillus isolates (CH3, CH4 and CH6) were evaluated for the production of antimicrobial substances like bacteriocins, organic acids and hydrogen peroxide using agar well diffusion technique with the slight modification described by Toure et al. [23]. The 25 ml of grown culture in MRS broth was divided into an equal portion for different assays. For Bacteriocin assay, 5 ml of supernatant treated with 1 mg/ml pronase or 1 mg/ml trypsin. For Organic acids assay, 5 ml of supernatant was adjusted to pH 6.5±0.1 using 1N NaOH and for hydrogen peroxide assay, 5 ml of supernatant was treated with 0.5 mg/ml catalase (Hi-media pvt ltd), treated supernatant were filtered with 0.22 µm pore size filters (Axiva pvt ltd) for bacteriocin assay. A volume of 50-100 µl was placed in 7-mm diameter wells; the plates were swabbed with 1% (v/v) overnight culture of each test pathogens. The inhibitory features were observed and measured the zone of inhibition after 24 h at 37 °C.
Determination of minimum inhibitory concentration
Minimum inhibitory concentration (MIC) was determined to evaluate the phenotypic antimicrobial resistance of a strain to a certain probiotic Lactobacillus isolates (Cell-free culture supernatant). MIC was defined as the lowest Lactobacillus sps concentration that resulted in no visible growth. This MIC test was determined by broth dilution technique by following the reference standard established by CLSI 2010. Serial two-fold dilutions (Higher and lower) of the CFCS Lactobacillus isolates were inoculated with an overnight culture at a final concentration of 107-108 colony forming a unit (CFU/ml). MIC level was determined by measuring the test pathogen’s absorbance at 600 nm and Lactobacillus-free broth used as a control.
Auto aggregation of probiotic Lactobacillus sps
Aggregation study was examined for effectively selected probiotic Lactobacillus isolates from cheese samples on the basis of their deposition properties. 18-24 h of fresh overnight cultures of each Lactobacillus isolates (108CFU/ml) were harvested by centrifugation at 6,000×g for 20 min, 4 °C, washed twice with Phosphate Buffer Saline (pH 7.2) and discarded in the same buffer. The auto aggregation percentage was calculated for three different Lactobacillus isolates after the mixture (vortexed) was incubated at 37 °C for 4 h without agitation.

Where Atime and AInitial measured at 600 nm, represents the absorbance of the mixture at 0 hr and 4 h.
Coaggregation of Lactobacillus sps with different test pathogenic cells
The co-aggregation study was examined for all three selected Lactobacillus isolates and different test pathogens according to a slight modified method to Collado et al. [24]. Bacterial cultures were separately cultured at 37 °C for 24hours in MRS and Tryptic Soya Broth (TSB). Bacterial suspension (108CFU/ml) were prepared as narrated in the auto aggregation as above method, an equal volume of cells of the different probiotic Lactobacillus sps and test pathogenic strains (1:1 v/v) were mixed and incubated at 37 °C without agitation. Absorbance, A600 of the mixture illustrate above, was conducted during the incubation at 4 h, percentage of coaggregation were calculated as-

Where, Apathogen and A lactobacillus and Amix represent the A600 of the individual pathogen, Lactobacillus sps and their mixture after incubation for 4 h, respectfully.
Time-kill assays with cell-free culture supernatant (CFCS) of Lactobacillus sps on test pathogens
The time–kill assay was performed by co-culture of each pathogenic cells and Cell-free culture supernatant (CFCS) of Lactobacillus sps,300 µl of pathogenic suspension (108CFU/ml) were added into 15 ml of CFCS of each different Lactobacillus isolates, CFCS adjusted to be pH and MRS broth to 6.5 respectively and were incubated at 37 °C. At initial and designed/planned intervals, fractions were separated by serially diluting and plated on Luria-Bertani (LB) agar to determine the surviving cells of individual pathogens.
Cell surface hydrophobicity
Cell surface hydrophobicity was revealed, following to the capability of the three different Lactobacillus sps and test pathogens to partition into xylene from PBS [25] individually. The cells were washed twice with PBS and the optical density (A) at 540 nm adjusted to 0.5±0.01 to 1.0 ml of bacterial suspension, 60 µl xylenes was added and vortexed for 1 min and the optical density of the water phase was determined. Percentage of hydrophobicity was calculated according to the formula.

Quantification of organic acid and determination of pH value
One percent (v/v) 24 h active culture of Lactobacillus isolates was used to inoculate 10% sterilized skim milk (Hi-media pvt ltd India) and initial pH 6.76 was determined by digital electrode pH meter. The inoculated skim milk was incubated at 37 °C for 72 h and samples were collected in every 12, 24, 48 and 72 h and liquids of coagulated milk were separated by filtration. pH of the separated liquid was recorded using a digital electrode pH meter and quantification organic acid was performed through titration with 0.1N NaOH.
RESULTS
Isolation and identification of Lactobacillus isolate
Over the study period, a total five different companies of cheese samples collected from commercially available at local milk vendors of the city market. Lactobacillus sps were isolated from 14 (50%) of the total twenty-eight bacterial strains, among the collected bacterial strains, Lactobacillus sps were predominantly isolated (table 1).
Table 1: Origin and number of isolates after screening for Lactobacillus sps
| Source of dairy product | No. of isolates | No. of Lactobacillus sps |
| Amul cheese | 13 | 5 |
| Mozzarella pizza cheese | 8 | 3 |
| Nilgiris Processed cheese | 5 | -- |
| Nilgiris cheddar cheese | 9 | 4 |
| Milky mist cheese | 7 | 2 |
| Total | 42 | 14(33.33%) |
14 strains (after culturing for 48h), were selected as forming wide and white colonies on the selective MRS agar plate (fig. 1),further, identified as Lactobacillus sps by observing their colony morphology, physiological as well as biochemical characterization(table 2). All the results clear that, bacteria were gram positive, rod shaped (fig. 2), non-motile and catalase negative. The confirmed Lactobacillus isolates were named as CH1, CH2, CH3, CH4, CH5, CH6, CH7, CH8, CH9, CH10, CH11, CH12, CH13 and CH14. These isolates were cultured on MRS with glycerol (30%) broth and stored at-20 °C.
Fig. 1: Typical characteristics of the Lactobacillus isolates grown on MRS agar medium. (A) Isolated Lactobacillus colonies and (B) Single screened colonies on MRS media
Table 2: Morphological, cultural and biochemical characteristics of isolated Lactobacillus sps from cheese samples
Selected Lactobacillus spp. |
Morphological and cultural characteristics |
Gram’s |
Motility test |
Catalase test |
Carbohydrate fermentation test |
|||
Glucose |
Sorbitol |
Sucrose |
||||||
Acid |
Gas |
|||||||
CH1 |
Small, irregular, smooth and circular |
Gram+ve, bacilli |
Non motile |
Negative |
-ve |
-ve |
+ve |
-ve |
CH2 |
Small, 0.1-0.5 mm, circular and round |
Gram+ve, bacilli |
Non motile |
Negative |
-ve |
-ve |
+ve |
-ve |
CH3 |
1 mm, White, shiny smooth, round |
Gram+ve, bacilli |
Non motile |
Negative |
-ve |
-ve |
+ve |
-ve |
CH4 |
Shiny, Small Circular, white creamy |
Gram+ve, bacilli |
Non motile |
Negative |
-ve |
-ve |
+ve |
-ve |
CH5 |
1.0 mm white, rough, irregular and round |
Gram+ve, bacilli |
Non motile |
Negative |
-ve |
-ve |
+ve |
-ve |
CH6 |
Small Circular, colourless |
Gram+ve, bacilli |
Non motile |
Negative |
-ve |
-ve |
+ve |
-ve |
CH7 |
Small, 0.1-0.5 mm, rough dull and round |
Gram+ve, bacilli |
Non motile |
Negative |
-ve |
-ve |
+ve |
-ve |
CH8 |
1.0 mm white, rough, irregular and round |
Gram+ve, bacilli |
Non motile |
Negative |
-ve |
-ve |
+ve |
-ve |
CH9 |
Small Circular, white creamy |
Gram+ve, bacilli |
Non-motile |
Negative |
-ve |
-ve |
+ve |
+ve |
CH10 |
Small, 0.1-0.5 mm, rough dull and round |
Gram+ve, bacilli |
Non motile |
Negative |
-ve |
-ve |
+ve |
-ve |
CH11 |
Small Circular, white creamy |
Gram+ve, bacilli |
Non-motile |
Negative |
+ve |
-ve |
+ve |
+ve |
CH12 |
1.0 mm white, rough, irregular and round |
Gram+ve, bacilli |
Non motile |
Negative |
+ve |
-ve |
+ve |
+ve |
CH13 |
Small, 0.1-0.5 mm, rough dull and round |
Gram+ve, bacilli |
Non motile |
Negative |
+ve |
-ve |
+ve |
+ve |
CH14 |
0.1-0.5 mm, white, irregular, smooth |
Gram+ve, bacilli |
Non motile |
Negative |
+ve |
-ve |
+ve |
+ve |
Five different companies of cheese samples (CH) collected from commercially available local milk vendors of the city market, Gulbarga, Karnataka (Number of isolated Lactobacillus sps from cheese samples: n=14).

Fig. 2: Microscopic observation of Gram’s stained Lactobacillus sps (Magnified at 100X)
Optical growth at different pH
All the isolated Lactobacillus sps of different sources of cheese samples shown maximum growth of the Lactobacilli isolated from Nilgiris cheddar cheese and mozzarella cheese was observed at pH5.0 to 6.5. The OD reading was the average value of the two samples (OD=2.980), as shown in the fig. 3.
Bile salt tolerance
The isolated Lactobacillus sps were capable of grow and survive in 0.05 to 2.5% of bile salt, at this bile concentration, all the Lactobacillus isolates were shown prompt multiplication in their populations as depicted in the fig. 4, optical density values against different bile salt concentration of each Lactobacillus isolates.

Fig. 3: Optimal growth and pH of isolated Lactobacillus isolates from Cheese samples, where CH-isolated Lactobacillus sps from cheese samples (n=14) at different pH (Error bars were omitted for simple and clear presentation)

Fig. 4: Bile acid tolerance of Lactobacillus isolates from Cheese samples, where CH-survival of isolated Lactobacillus sps from cheese samples (n=14) in 0.05 to 2.5% of bile salt (Error bars were omitted for simple and clear presentation)
NaCl tolerance test
All the selected Lactobacillus sps from different cheese samples were able to tolerate different NaCl concentrations i.e. 1-6%, results as shown in the fig. 5.

Fig. 5: NaCl tolerance of Lactobacillus isolates from Cheese samples, where CH-survival of isolated Lactobacillus sps from cheese samples (n=14) at different NaCl concentration (Error bars were omitted for simple and clear presentation)
Antibiotic susceptibility test
The antibiotic susceptibility test was carried out for all 14 positive Lactobacillus sps against the 16 antibiotics consisted of different classes. Maximum lactobacillus isolates 10 (71.42%) were shown resistance to the antibiotic; ampicillin, 11(78.57%)sensitivity to the antibiotic amoxiclav and 5 (35.71%) intermediate to the antibiotic erythromycin, the results as shown in the fig. 6 and table 3.
Antimicrobial (antagonistic) activity of Lactobacillus isolates
Antimicrobial activity is one of the main features of probiotic bacteria. For this reason, all the fourteen Lactobacillus isolates were examined for their potential inhibitory effects against different test pathogenic organisms (included gram positive and gram negative bacteria) such as Staphylococcus aureus, Enterococcus faecalis, Klebsiella pneumonia, Pseudomonas aerogenosa, Escherichia coli, Salmonella typhii and Shigella spp. using modified agar-well diffusion method. The results exhibited that all the isolates of Lactobacillus revealed the average inhibition (10-24 mm) on the growth of test pathogen, but the Lactobacillus isolates like CH3, CH4 and CH6 was the most effective noticeable isolates in inhibiting the growth of test pathogens (17-24 mm) than the reference strains of Lactobacillus fermentum NCDC 141 (fig. 7 and table 4a).
Further, Lactobacillus isolates were subjected for bacteriostatic or bacteriocidal, this confirmation test was done by modified agar overlaid method were conducted, swabs were taken from each clear zone of the test organism and were streaked onto the nutrient agar for growth. Based on the growth bacteriostatic and bacteriocidal activities are exhibited in table 4b. The presence of growth of test pathogen was confirmed as an inhibitory activity called bacteriostatic if no growth concludes as bacteriocidal.
Fig. 6: Antibiotic susceptibility pattern of Lactobacillus isolates (A). Sensitive pattern, (B). Resistant pattern
Table 3: Antibiotic susceptibility test for Lactobacillus isolates
| S. No. | Antibiotics Used | No. of resistance | No. of sensitive | No. of intermediate |
| 1 | Ampicillin | 10 (71.42%) | -- | 4 (28.57%) |
| 2 | Amikacin | 7 (50%) | 7 (50%) | -- |
| 3 | Amoxyclav | 2 (14.28%) | 11 (78.57%) | 1 (6.25%) |
| 4 | Azithromycin | 9 (64.28%) | 4 (25.00%) | 1 (7.14%) |
| 5 | Ceftriaxone | 7 (50%) | 6 (42.85%) | 1 (7.14%) |
| 6 | Chloramphenicol | 8 (57.14%) | 6 (42.85%) | -- |
| 7 | Ciprofloxacin | 6 (42.85%) | 8 (57.14%) | -- |
| 8 | Clindamycin | 8 (57.14%) | 6 (42.85%) | -- |
| 9 | Cotrimoxazole | 5 (35.71%) | 9 (64.28%) | -- |
| 10 | Erythromycin | 5 (35.71%) | 4 (28.57%) | 5 (35.71%) |
| 11 | Gentamycin | 6 (42.85%) | 8 (57.14%) | -- |
| 12 | Neomycin | 6 (42.85%) | 8 (57.14%) | -- |
| 13 | Novobiocin | 7 (50.00%) | 7 (50.00%) | -- |
| 14 | Streptomycin | 7 (50.00%) | 7 (50.00%) | -- |
| 15 | Sulfamethizole | 7 (50.00%) | 7 (50.00%) | -- |
| 16 | Tetracycline | 5 (35.71%) | 8 (57.14%) | 1 (7.14%) |
Among the 14 positive Lactobacillus sps, 10(71.42%) Lactobacillus isolates were shown resistance to the antibiotic; ampicillin, 11 (78.57%) sensitivity to the antibiotic amoxiclav and 5 (35.71%) intermediate to erythromycin

Fig. 7: Antimicrobial (antagonistic) activity of Lactobacillus isolates against different test pathogens, A. Gram-positive B. Gram-negative
Table 4a: Antagonistic activity of Lactobacillus isolates against test pathogens fromCheese samples
Lactobacillus isolates |
Zone of Inhibition in mm (from outer edge of Lactobacillus colony to outer edge of clear zone) |
||||||
S. aureus |
S. typhi |
E. coli |
E. faecalis |
K. pneumoniae |
P. aerogenosa |
Shigella spp. |
|
CH1 |
11 |
12 |
11 |
10 |
12 |
10 |
11 |
CH2 |
12 |
12 |
10 |
11 |
11 |
13 |
12 |
CH3 |
18 |
19 |
17 |
16 |
22 |
19 |
19 |
CH4 |
20 |
16 |
14 |
14 |
20 |
16 |
16 |
CH5 |
14 |
14 |
14 |
13 |
17 |
13 |
14 |
CH6 |
24 |
17 |
19 |
20 |
20 |
17 |
18 |
CH7 |
10 |
12 |
10 |
11 |
12 |
11 |
13 |
CH8 |
17 |
14 |
17 |
12 |
16 |
16 |
16 |
CH9 |
16 |
15 |
14 |
13 |
17 |
16 |
13 |
CH10 |
16 |
14 |
11 |
14 |
19 |
12 |
11 |
CH11 |
12 |
11 |
13 |
12 |
11 |
10 |
12 |
CH12 |
11 |
10 |
11 |
11 |
10 |
11 |
13 |
CH13 |
10 |
11 |
12 |
12 |
12 |
12 |
14 |
CH14 |
15 |
12 |
10 |
12 |
11 |
11 |
12 |
Isolates of Lactobacillus shown the average inhibition (10-24 mm) on the growth of test pathogen, CH3, CH4 and CH6 was the most effective noticeable isolates in inhibiting the growth of test pathogens (17-24 mm). All the Lactobacillus isolates were shown the average inhibition activity (10-24 mm), Where, CH3, CH4 and CH6 isolates shown effective Antagonistic activity (17-24 mm) against different test pathogens
Table 4b: Bacteriostatic and bactericidal activity of cheese isolates (CH3, CH4 and CH6)
| Name of the pathogens | CH3 isolate | CH4 isolate | CH6 isolate |
| S. aureus | - | - | + |
| E. faecalis | + | + | _ |
| E. coli | _ | _ | _ |
| P. aerogenosa | _ | + | + |
| K. pneumoniae | + | _ | + |
| S. typhii | + | + | _ |
| Shigella spp | _ | - | - |
Where,+= Bacteriostatic,-= Bacteriocidal
Characterization of inhibitory substances
The effectively collected Lactobacillus isolates (CH3, CH4 and CH6) were evaluated for the characterization of inhibitory substances like bacteriocin, organic acid and hydrogen peroxide. This test was characterized by agar well diffusion assay against test pathogens. The results exhibited that culture supernatant of all three Lactobacillus sps and there reference strains treated with pronase (1 mg/ml) or trypsin (1 mg/ml) did not have any inhibitory activities effects of the Lactobacillus sps. This confirms that inhibitory effect of Lactobacillus isolates was due to bacteriocin production. Culture supernatants treated with catalase also did not affect the inhibitory activities of the Lactobacillus strains against the test pathogens. This showed that inhibition by the Lactobacillus strains was not due to hydrogen peroxides production.
However, neutralized supernatant (pH 6.5) of all three Lactobacillus strains did not have any inhibitory activity effects of the Lactobacillus strains were due to their organic acid production. Hence, this study concludes that among three Lactobacillus isolates CH3 isolate was bacteriocin and CH4, CH6 isolates were responsible for organic acid production respectfully (fig. 8 and table 5).
Fig. 8: Antimicrobial activity of Lactobacillus (CFCS) Inhibitory substances against test pathogen, (A). Bacteriocin (B). Organic acid
Table 5: Characterization of antimicrobial substances of selected cheese isolates
Shigella selected Strains |
CH3 (in mm) |
CH4 (in mm) |
CH6 (in mm) |
|||
Bacteriocin assay |
Organic acid assay |
Bacteriocin assay |
Organic acid assay |
Bacteriocin assay |
Organic acid assay |
|
S. aureus |
23 |
- |
- |
16 |
- |
12 |
E. faecalis |
- |
17 |
- |
12 |
- |
10 |
E. coli |
20 |
- |
- |
19 |
- |
17 |
P. aerogenosa |
- |
21 |
- |
14 |
- |
16 |
K. pneumoniae |
- |
- |
- |
11 |
- |
15 |
S. typhii |
18 |
19 |
- |
10 |
- |
19 |
Shigella spp |
19 |
15 |
- |
16 |
- |
19 |
Neutralized supernatant of (pH 6.5) of all three Lactobacillus strains did not have any inhibitory activity effects. Among three Lactobacillus isolates CH3 isolate was bacteriocin and CH4, CH6 isolates were responsible for organic acid production. All the selected Lactobacillus isolates were subjected for the production of antimicrobial substances, CH4 and CH6 isolates were responsible for the production of only Bacteriocin, whereas CH3 isolate shown the production for both Bacteriocin and Organic acid against test pathogens.
Determination of minimal inhibitory concentration
All three Lactobacillus isolates were used for MIC test, the results clear that MIC for CH3 isolate was 50 µl against E. faecalis, S. typhii, S. aureus, k. pneumoniae, E. coli and p. aerogenosa, 100 µl for Shigella sps, for CH4 isolate 75 µl for k. pneumoniae, E. coli, p. aerogenosa and 100 µl for E. faecalis, S. typhii, S. aureus and Shigella sps and for CH6 isolate 128 µl for S. typhii, S. aureus, Shigella sps, E. faecalis and 100 µl for k. pneumoniae, E. coli, p. aerogenosa.
Auto and co-aggregation of probiotic Lactobacillus sps
The autoaggregation study was investigated for all three Lactobacillus isolates and different test pathogens based on their deposition capacity. The results exhibited that, among the three, CH3 isolate promptly noticed the highest percentage of auto aggregation after 24 h of the incubation period (51%) as compared to CH4 and CH6 isolates as shown in the table 6a.
The coaggregation results of the Lactobacillus isolates tested with different test pathogens as shown in the table 6b. This study is strain-specific as compared to aggregation, among the isolates, CH3, CH4 and CH6 isolates, showed the effective coaggregation with Shigella sps as 19.3, 17.4 and 20.4% respectfully, similarly CH4 isolate showed the less coaggregation abilities with S. aureus, also the other test pathogens used.
Table 6a: Percentage of autoaggregation of Probiotic selected isolates with pathogenic strains
Lactobacillus Strains |
Auto-aggregation (%) |
||
|
4h |
18h |
24h |
CH3 isolate |
21±2.3 |
29±3.4 |
47±2.8 |
CH4 isolate |
14±2.5 |
21±2.5 |
38±2.7 |
CH6 isolate |
11±1.1 |
27±1.2 |
45±1.7 |
Pathogenic strains |
|
||
Staphylococcus aureus |
2.9±1.0 |
3.8±0.1 |
5.0±0.9 |
Enterococcus faecalis |
2.2±1.4 |
2.9±0.4 |
3.9±0.8 |
Escherichia coli |
7.2±1.2 |
12.1±0.8 |
16±1.2 |
Pseudomonas aerugenosa |
3.5±0.8 |
11.1±1.1 |
20±1.5 |
Klebsiella pneumoniae |
5.1±1.1 |
11±1.3 |
17±1.1 |
Salmonella typhi |
2.8±0.8 |
10±0.9 |
19±0.1 |
Shigella spp. |
2.1±0.4 |
9.7±0.1 |
20±1.0 |
Each value is expressed in mean±SD (n=6 in each test group). Auto-aggregation is expressed in terms of Percentage (%) at 4, 18 and 24 h.
Table 6b: Percentage of coaggregation of Lactobacillus isolates with test pathogens
Selected Lactobacillus strains |
Percentage of Co-aggregation with indicator strains |
||||||
S. aureus |
E. faecalis |
E. coli |
P. aeroginosa |
K. pneumoniae |
S. typhii |
Shigella spp. |
|
CH3 isolate |
18.2±2.1 |
10.8±0.7 |
17.8±0.4 |
14±0.7 |
14±2.1 |
19±0.6 |
19.3±5.3 |
CH4 isolate |
2.3±3.2 |
9.3±0.3 |
6.3±1.1 |
2.8±0.6 |
9±0.5 |
8±0.4 |
17.4±4.6 |
CH6 isolate |
12.2±1.5 |
16.7±0.5 |
15.2±0.5 |
8.2±0.8 |
11±1.1 |
11±0.3 |
20.4±1.4 |
Each value is expressed in mean±SD (n=6 in each test group). Strain-specific Co-aggregation is expressed in terms of Percentage (%) at 24 h.
Time-kill assays with cell-free culture supernatant (CFCS) of Lactobacillus sps on test pathogens
Time-kill assay showed the reduction in the cell counts of the different test pathogens in the presence of CFCS of each of Lactobacillus isolated; CH3, CH4 and CH6 covering 2-3 fractions of different incubation periods (6, 12,18and 24 h). The inhibition activity was more noticeable in the case of CH3 isolate as increasing in the incubation periods and as compared with other Lactobacillus CH4 and CH6 isolates. The study concluded that inhibitory substances like bacteriocin and organic acid presented in the CFCS of isolates were the responsible.
Cell surface hydrophobicity
Cell surface hydrophobicity was determined to study possible alliance between physicochemical property and its effective adherence to the intestinal mucus. The results cleared that, cell-surface hydrophobicity changes with the test pathogens used, in the selected Lactobacillus isolates, CH3 isolate (53%) was highest hydrophobic in nature, as compared to the other selected isolates were lesser or no hydrophobicity towards xylene from the control taken as 0%. Among the test pathogens used, Shigella spp and E. coli (29 and 24.4% respectively) exhibited better hydrophobicity percentage, Pseudomonas aerogenosa and Salmonella typhii (18.2and16.4%respectively), but Klebsiella pneumonia, Staphylococcus aureus and Enterococcus faecalis (8.4, 6.2and 3% respectively) appeared less percentage of hydrophobicity as shown in table 7.
Quantification of organic acid and determination of pH value
The identified Lactobacillus species from Cheese samples CH3, CH4 and CH6 coagulated the skim milk and produced organic acids in the sterilized skim milk which were observed by the titrimetric method of different incubation periods. The results were showed in table 8.
Table 7: Percentage of Cell surface hydrophobicity of bacterial strains
| Selected strains | Cell–surface hydrophobicity (%) |
| CH3 | 53.0±0.1 |
| CH4 | 27±0.5 |
| CH6 | 31±1.0 |
| Test pathogens | |
| Staphylococcus aureus | 6.2±0.1 |
| Enterococcus faecalis | 3±0.2 |
| E. coli | 24.4±0.1 |
| Pseudomonas aeruginosa | 18.4±1.6 |
| Klebsiella pneumoniae | 8.4±0.1 |
| Salmonella typhi | 16.2±0.1 |
| Shigella spp. | 29.0±0.1 |
Each value is expressed in mean±SD (n=6 in each test group). Cell surface hydrophobicity is expressed in terms of Percentage (%) to each bacterial strain.
Table 8: Quantification of organic acid and determination of pH value of selected Lactobacillus sps
| Sources of Bacteria | Name of the bacteria | Incubation time (Hour) | Incubation temp. ( °C) | Organic acid (%) | pH |
| Cheese | CH3 | 12 | 37±2 | 0.3±0.05 | 5.74±0.5 |
| 24 | 37±2 | 0.34±0.03 | 5.01±034 | ||
| 48 | 37±2 | 0.39±0.06 | 4.68±0.62 | ||
| 72 | 37±2 | 0.39±0.05 | 4.52±0.66 | ||
| CH4 | 12 | 37±2 | 0.10±0.04 | 5.46±0.4 | |
| 24 | 37±2 | 0.21±0.02 | 5.13±0.23 | ||
| 48 | 37±2 | 0.28±0.06 | 4.72±0.22 | ||
| 72 | 37±2 | 0.33±0.05 | 4.51±0.49 | ||
| CH6 | 12 | 37±2 | 0.18±0.05 | 5.68±0.44 | |
| 24 | 37±2 | 0.22±0.07 | 5.24±0.62 | ||
| 48 | 37±2 | 0.28±0.02 | 4.72±0.28 | ||
| 72 | 37±2 | 0.30±0.09 | 4.48±0.45 |
Organic acids in the sterilized skim milk and evaluation of pH for CH3, CH4 and CH6 Lactobacillus sps were quantified by the titrimetric method of different incubation periods (12, 24, 48 and 72 h). The quantity of organic acid is expressed in terms of Percentage (%). Quantification of Organic acids was done by the titration method of all selected Lactobacillus isolated (CH3, CH4 and CH6) and determined their pH and percentage of organic acid production at different intervals of incubation periods (12, 24, 48 and 72 h). Where, each value is expressed in mean±SD (n=6 in each test group).
DISCUSSION
The present study was aimed to isolate, identify and characterize the effective probiotic Lactobacillus sps from different companies of cheese samples, which are commercially available at the local milk vendors in city market of Gulbarga. The study exhibited that, CH3, CH4 and CH6 Lactobacillus isolates (among 14 Lactobacillus isolates) considered as potential and novel probiotic bacteria to determine their antagonistic activity against common human test pathogens. On the basis of cultural and morphological characteristics [26] of all three selected Lactobacillus isolates which are separately isolated from different cheese samples. After gram staining the isolated bacteria were rod-shaped, convex, smooth, rough, non-motile and gram positive, (table 2) which cleared the member of Lactobacillus sps [27].
Optimum growth of the isolates was noted at pH 5.0 to 6.5 on MRS plates in anaerobic conditions, all the Lactobacillus isolates were catalase and oxidase negative, the results are in similar characterization criteria with Elizete and Carlos [28]. Most of the Lactobacillus isolates examined in this study (80-85%) were capable of fermenting glucose, sucrose, and sorbitol illustrates that they were able to grow in a variety of habitats using a different type of carbohydrates. Concerning to the better and potential probiotic bacteria must be capable of growing in acidic environments. The present work established the impelled gastric juice caused no appropriate decreases in viabilities of the Lactobacillus isolates; these isolates were likely to survive in an acidic environment of the intestine.
The pH in the human stomach ranges from 1.5 to 4.5 depending on the intervals of feeding, the types of food consumed, and the duration of food digestion, which can take up to 3-4 h. As the results in fig. 3 exhibits, all the collected Lactobacillus sps showed high and maximum isolates were tolerated to the range of pH and grow well in the acidic pH. These important observed results are in agreement with those reported by Burns et al. [29]. Bile salts also consider the important factor for considering the Lactobacillus sps viability [30]. Isolates isolated from cheese samples was resistant to 0.5% bile salt, and all the isolates were able to survive and grow in 0.5% bile salt concentration up to the tested incubation period; 18h (fig. 4). This study also clears that, all of the isolates were also tolerate 1-6% NaCl and good growth at 1-5% of NaCl (fig. 5). In addition, inhibition of pathogenic strain growth is one of the adorable properties of probiotic bacteria. Pathogens can be combative through the production of antimicrobial compounds such as bacteriocin, organic acid, hydrogen peroxide, which competes for pathogen binding and receptor sites as well as for available nutrients and growth factors (17, 31). Under our experimental circumstances, almost Lactobacillus isolates exhibited the clear zone for the pathogens used and presented different antipathogenic activities. Over these results, we can expect human healthcare to benefit, improving protection against occurrences of diarrhea, enteric infection and improvement of our intestinal flora. As shown in the fig. 6, maximum Lactobacillus isolates showed sensitive to the antibiotic used. Hence, these Lactobacillus isolates were considered for further in vitro activities. Aggregation and co-aggregation study of the Lactobacillus isolates and different pathogenic strains having the role in several factors. The results of this study exhibited that, aggregation time increases as a concern and were highest at the 4 h of incubation time period (table 6a and 6b).
CONCLUSION
Lactobacillus strains isolated in this study from the different dairy samples have in vitro properties that make them potential candidates for probiotic applications. Among the strains, Lactobacillus isolates from cheese predominantly exhibited interesting probiotic properties such as excellent pH and bile tolerance, aggregations, suppression of pathogen growth under in vitro conditions. Moreover, all tested strains were susceptible to a number of clinically effective antibiotics. These results collectively suggest that isolates from cheese have promising properties that are important for potential probiotics. Hence, more research is needed to exploit other potential probiotic properties of these strains. Further, in vivo trials are needed to determine whether they function as probiotics in real life situations for human health benefits.
ACKNOWLEDGMENT
The authors are (Kelmani Chandrakanth Revanasiddappa and Prabhurajeshwar Chidre) profusely thankful to the Department of Biotechnology (grant from DBT, Govt. of India, BT/PR1812/SPD/24/577/2011) for funding the project and Department of Biotechnology, Gulbarga University, Gulbarga for providing facilities for pursuing the research work at the Department.
CONFLICT OF INTERESTS
We declare that no conflict of interest
REFERENCES
- Aslam S, Qazi JI. Isolation of acidophilic lactic acid bacteria antagonistic to microbial contaminants. Pak J Zool 2010;42:567-73.
- Tambekar DH, Bhutada SA, Choudhary SD, Khond MD. Assessment of potential probiotic bacteria isolated from milk of domestic animals. J Appl Biosci 2009;15:815–9.
- Castillo NA, Perdigón G, de LeBlanc AdM. Oral administration of a probiotic Lactobacillus modulates cytokine production and TLR expression improving the immune response against Salmonella enterica serovar Typhimurium infection in mice. BMC Microbiol 2011;11:177.
- Dixit G, Samarth D, Tale V, Bhadekar R. Comparative studies on potential probiotic characteristics of Lactobacillus acidophilus strains. Eurasia J Biosci 2013;7:1–9.
- Sumi das P, Bhattacharya MK, Prasad HK, Upadhyaya H, Pal K, Sharma GD, et al. Antimicrobial activity of Lactobacillus fermentum, a volvo vaginal isolate. Asian J Pharm Clin Res 2015;8:371-2.
- Gareau MG, Sherman PM, Walker WA. Probiotics and the gut microbiota in intestinal health and disease. Nat Rev Gastroenterol Hepatol 2010;7:503–14.
- Hemal S, Jayantilal D, Bharat kumar RM. Screening of potentially probiotic Lactobacillus strains isolated from fermented foods, fruits and of human origin. Asian J Pharm Clin Res 2014;7:216-25.
- Fuller R. Probiotics in man and animals. J Appl Bacteriol 1989;66:365-78.
- Fuller R. Probiotics: the scientific basis Chapman and Hall, London; 1992. p. 398.
- Holzapfel WH, Haberer P, Geisen RJ, Björkroth, Schillinger U. Taxonomy and important features of probiotic microorganisms in food nutrition. Am J Clin Nutr 2001;73:365-73
- Vernoux JP, Coeuret V, Dubernet S, Bernardeau M, Gueguen M. Isolation, characterization and identification of lactobacilli focusing mainly on cheeses and other dairy products. EDP Sci-Inra 2003;83:269-306.
- Oskar A, Meydani SN, Russell RM. Yogurt and gut function. Am J Clin Nutr 2004;80:245-56.
- Tannock G. A special fondness for lactobacilli. Appl Environ Microbiol 2004;70:3189-94.
- Catanzaro J, Green L. Probiotics in human medicine (Part II). Altern Med Rev 1997;2:296-305.
- Walker DK, Gilliland SE. The relationship among bile tolerance, bile salt deconjugation, and Lactobacillus casei, Lactobacillus rhamnosus and assimilation of cholesterol by Lactobacillus acidophilus. J Dairy Sci 1983;76:956-61.
- Kilara A. Influence of in vitro gastric digestion on the survival of some lactic cultures. J Dairy Sci 1982;37:129-32.
- Petros A, Maragkoundakis PA, Zoumpopoulou G, Miaris C, Kalantzopoulos G, Pot B, et al. Probiotic potential of Lactobacillus strains isolated from dairy products. Int Dairy J 2006;16:189-99.
- Pennacchia C, Ercolini D, Blaiotta G, Pepe O, Mauriello G, Villani F, et al. Selection of Lactobacillus strains from fermented sausages for their potential use as probiotics. J Meat Sci Bark 2004;67:309-17.
- Giilliland SE, Staley TE, Bush LJ. The importance of bile tolerance of Lactobacillus acidophilus used as a dietary adjunct. J Dairy Sci 1984;67:3045-51.
- Bauer AW, Kirby WM, Sherris JC, Turck M. Antibiotic susceptibility testing by standard single disc method. Am J Clin Pathol 1996;45:493–6.
- National Committee for Clinical Laboratory Standards, author. Tentative Guidelines, M26-TNCCLS: Villanova; 1993.
- Ashraf M, Arshad M, Siddique M, Muhammad G. In vitro screening of locally isolated Lactobacillus species for probiotic properties. Pak Vet J 2009;29:186-90.
- Toure R, Kheadr E, Lacroix C, Moroni O, Fliss I. Production of antibacterial substances by Bifidobacterial isolates from infant stool active against Listeria monocytogenes. J Appl Microbiol 2003;95:1058–69.
- Grześkowiak L, Collado MC, Salminen S. Evaluation of aggregation abilities between commensal fish bacteria and pathogens. Aquac 2012;356:412–6.
- Gotcheva V. Assessment of potential probiotic properties of lactic acid bacteria and yeast strains. J Food Biotech 2002;16:211-25.
- Osuntoki AA, Ejide OR, Omonigbehin EA. Antagonistic effects on Enteropathogenic and plasmid analysis of Lactobacilli isolated from fermented Dairy products. Biotechnology 2008;7:311-6.
- Holt JG, Krieg NR, Sneath PHA, Staley JT, Williams ST. Bergey’s manual of Determinative Bacteriology: Baltimore; 1994.
- Elizete DFRP, Carlos RS. Biochemical characterization and identification of probiotic Lactobacillus for swine. B CEPPA Curitiba 2005;23:299-10.
- Burns P, Patrigani F, Serrazanetti D, Vinderola GC, Reinheimer JA, Lanciotti R, et al. Probiotic Crescenza cheese containing Lactobacillus casei and Lactobacillus acidophilus with high-pressure homogenized milk. J Dairy Sci 2008;91:500-12.
- Begly M, Gahan CG, Hill C. The interaction between bacteria and bile. FEMS Microbiol Rev 2005;29:625-51.
- Makras L, De Vuyst L. The in-vitro inhibition of pathogenic gram-negative bacteria by Bifidobacteria is caused by the production of organic acids. Int Dairy J 2006;16:1049-57.
How to cite this article
- Prabhurajeshwar C, Kelmani Chandrakanth R. Development of in vitro methodologies for inhibition of pathogenic bacteria by potential probiotic Lactobacillus SPS; evidence for production of antimicrobial substances. Int J Pharm Pharm Sci 2016;8(12):277-286.